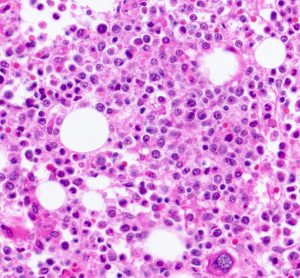

EMA’s human medicines committee (CHMP) May 2022 meeting highlights
The latest meeting saw EMA’s human medicines committee (CHMP) recommend the approval of nine new medicines, refuse two biosimilar medications and recommend extensions of therapeutic indication for six medicines.